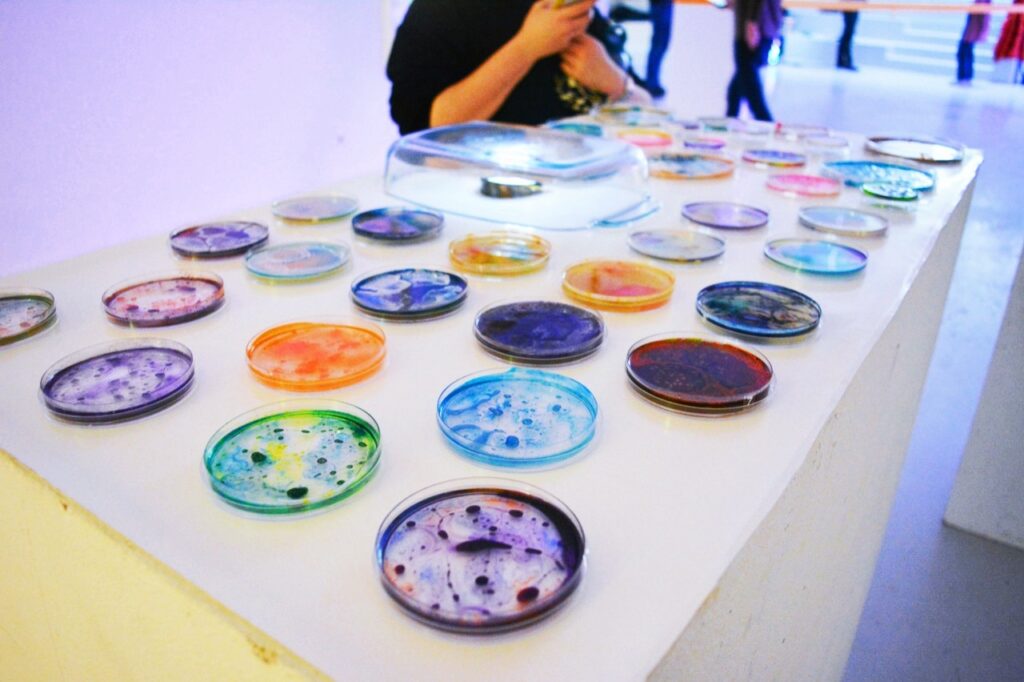
Beautiful Bacteria by Lianne Regtuit petri dishes on display

Beautiful Bacteria
Showing a different perspective
by Lianne Regtuit
Info
“Beautiful Bacteria” is an artistic project that invites viewers to look differently at something often misunderstood: bacteria. While bacteria are commonly associated with filth or illness, they are in fact essential to all life on Earth. This project challenges those negative perceptions by highlighting the visual and biological beauty of microorganisms.
The inspiration for this project emerged during the COVID-19 pandemic. At the time, I worked a temporary job in a laboratory that developed nutrient media for bacterial cultures. I was involved in the production of transport tubes for coronavirus tests. I chose to do this job because I had long been intrigued by laboratory work. My curiosity deepened while working in this environment, particularly in relation to bacteria and fungi.
As I learned more about how growth media are made, I was allowed to use Petri dishes from the lab for my own experiments. At first, culturing actual bacteria for an art project wasn’t exactly encouraged. So I began by simulating bacterial growth using various materials. Through experimentation, I discovered a striking effect: when alcohol ink is dropped into demineralized water, it dries into patterns that closely resemble bacterial colonies. These abstract, organic forms became the visual foundation of the project.
Over time, I was permitted to work with real bacteria under controlled conditions. Some pre-infected Petri dishes were provided by the lab, but only after quality control had identified which strains were present. Using these plates, I conducted a series of experiments by pouring nutrient agar into resin (epoxy) and combining it with pigments like alcohol ink and acrylic paint. This approach led to unexpected and delicate patterns, blending scientific material with artistic technique.
During my exhibition, visitors were invited to place the Petri dishes on light sources, allowing them to explore the intricate details and textures and to appreciate bacteria not as something dirty, but as something fascinating and, perhaps, even beautiful.
Lianne Regtuit
Biobased Art & Design
Contact
Do not hesitate to contact me to discuss a possible project or learn more about my work.
© 2025 Lianne Regtuit